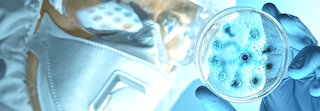
air humidification in clean rooms @

In many industries, parts of the production will take place in adjustable, air-conditioned clean rooms. Legal requirements mean that specially prepared, air-conditioned rooms are essential for processes such as semiconductor manufacturing, medical research, pharmaceuticals, life sciences and nanotechnology to constantly regulate air humidity.
For comparable, consistent and functional results, those working in laboratories and clean rooms require stable, controllable atmospheric conditions. Temperature and relative humidity play an important role as they influence the viscosity and usability of materials, as well as the speed of chemical reactions. These climatic conditions also prevent the proliferation of bacteria and other biological contaminants.
A comfortable environment of 40-60% relative humidity is ideal for people working in laboratories and clean rooms as it boosts productivity and significantly reduces employee health-related absences.